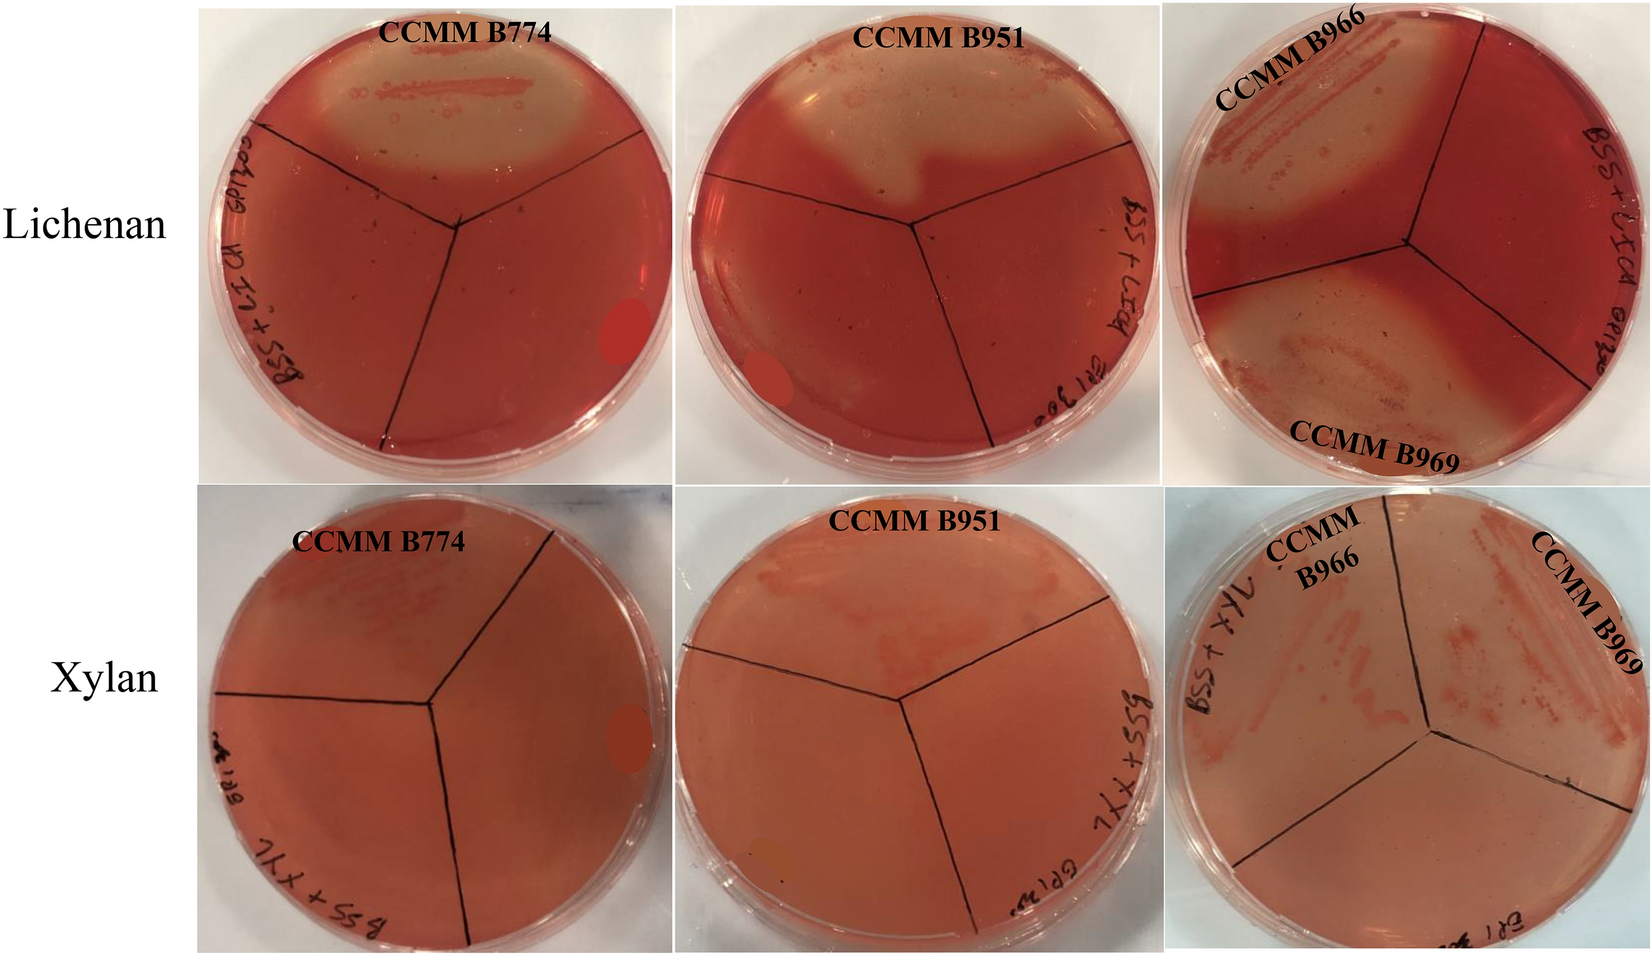
Figure 1

Figure 1
Detection of lichenase and xylanase activities of Bacillus CCMM strains grown in BSS agar medium supplemented with 0.5% (w/v) lichenan or xylan for 48 h at 37 °C. Congo red staining revealed clear halos around the streaks in the presence of enzymatic activities.